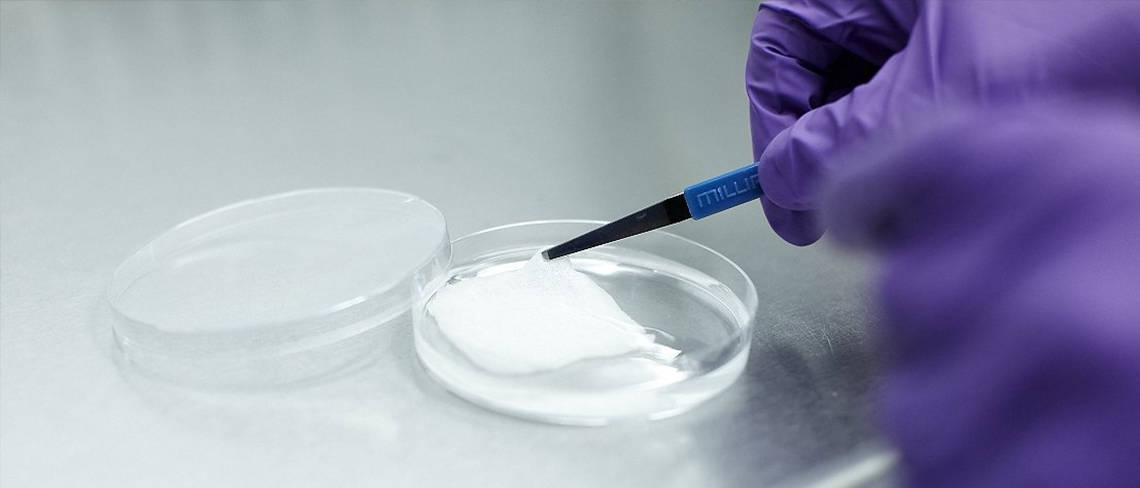

New Artificial Skin Trials Offer Hope to Acid Attack Victims
The horrific increase in the number of acid attacks in the UK has given medical research trust RAFT even more reason to back its latest next generation artificial skin called Smart Matrix® which was specially invented to help burns victims.
Smart Matrix® is a potentially revolutionary treatment for wounds that may not heal naturally and could potentially be a life-changing breakthrough for acid attack victims and other burns patients in the future.
The artificial skin is composed of a porous matrix made of human fibrin: a protein produced naturally in the body essential for early wound closure that harnesses the body’s own healing processes. It is naturally absorbed into the body as the wound heals.
Leonor Stjepic, RAFT Chief Executive said: “Smart Matrix® is a sponge-like scaffold technology that encourages the growth of skin cells and blood vessels and helps the body close a wound and regenerate.
“The precise combination of constituent elements, their chemical processing and the design of the physical structure, took years to perfect. Unlike existing scaffolds, its aim is to help the wound heal without the application of a painful and costly overlying skin graft and has already been tested and shown to be safe in humans.”
Currently, surgical excision wounds are frequently treated with a split thickness skin graft that creates a secondary wound which often leads to significant stress for the patient and hefty financial costs to the healthcare system.
Other disadvantages of a split thickness skin graft include: an increased risk of infection; graft failure or rejection; increased surgical time; prolonged healing; a risk of scarring and loss of mobility or poor cosmetic appearance of the wound. Not surprisingly, surgeons turned to RAFT to ask their team of scientists to find a better solution.
Preliminary trials in humans conducted to date have shown that Smart Matrix®:
- Has a durable and flexible construction to enable easy application with minimal wastage.
- May remove the need for a skin graft, avoiding the creation of a painful secondary wound at the donor site.
- May improve healing quality; in terms of elasticity, flexibility, colour match and contour in comparison to a skin graft
The health economic benefits of using Smart Matrix® may be also be substantial:
- Potential reductions in hospital length of stay
- Potential reductions in time spent in the operating theatre
- Potential reductions in the risk of wound infections and the cost of managing them
Patients have already described wounds treated with Smart Matrix® as being easy to maintain following the first clinical trial, raising the possibility of patients managing after-care themselves, which would further reduce healthcare costs.
Pre-clinical work has been successfully concluded and Smart Matrix® is now planning to move into a second clinical phase. If successful, a clinical trial planned to start early in 2018 will provide the necessary data to support an application for a CE mark (EU) and to set a pathway to FDA-approval (US).
The advances in Smart Matrix® couldn’t come at a better time as the number of crimes using acid or other corrosive substances has more than doubled in London over the last
three years, according to official data released by the Metropolitan Police. The figures revealed that more than 1,800 attacks involving corrosive fluid have been reported since 2010 with the number of reported attacks in London rising from 261 in 2015 to 454 in 2016, a rise of 74 per cent.
More than 25,000 chemicals are commonly used in industry, agriculture and house-hold cleaners and many of them have been identified as having the potential to cause burns.
The rising number of acid attacks have led to discussions around stricter regulations for buying and selling corrosive substances and Home Secretary Amber Rudd has promised to review sentencing guidelines, with acid attack perpetrators potentially facing life in prison.
The body has very few specific protective and repair mechanisms for burns which is why medical advances are so crucial. Although denaturation of proteins is a common effect of all type of burns, chemical injuries are often more severe than thermal injuries because there is often longer exposure to corrosive substances.
The duration of the chemical’s contact with the skin is the major determinant of injury severity and chemical burns are characterized by ongoing tissue destruction for as long as the inciting agent is present. Because of this, the immediate removal of the agent or any affected clothing and a thorough irrigation with water at the scene is vital.
RAFT Scientist Stuart Brown said: “As well as causing great damage due to its chemically corrosive nature, highly concentrated sulphuric acid can soar to boiling point when it comes into contact with water and because the human body is composed of around 60 per cent water this can cause agonising pain and burns for a victim if it comes contact with the skin.
“An acid attack victim would at first feel a hot sensation before suffering agonising pain as the skin starts to burn as the acid reacts with the water in the skin. It’s a very quick process and can only take a few seconds as the skin swells and then contracts.
“Because of how acid reacts when brought into contact with water, people may not realise but you actually need to use a large amount of water to wash any acid off. If you try to do it slowly with a small amount of water then it can actually make it worse because of the chemical reaction and heating effect.
Irrigation should be copious, and to the floor or in a special tank for runoff water, avoiding placing the patient into a tub, which could spread the corrosive agent to previously unexposed tissue and increase the damage.
“Obviously, the long-term treatment for burns victims is essential and this is where SmartMatrix@ will give surgeons new treatment options to help increase the healing process and improve the final appearance of the wound which is especially important for exposed areas like the face, which are often most affected in acid attacks.”
The first target market for Smart Matrix® will be surgical wounds – a market comprising 17.5m procedures per annum. But possible further wound applications for Smart Matrix include: severe burns, chronic wounds, traumatic injuries, military wounds and ulcers.
RAFT Patron, celebrity chef and former burns victim Peter Gordon said: “What RAFT is doing is wonderful and I have nothing but admiration for the team. I was in hospital three times as a child for extended periods and to lose that time was tough. It’s incredible to know there will be quicker healing times and a lot less scarring for future patients thanks to the amazing research happening at the moment. If I suffered the same injuries now, I’m reassured I’d be treated in a very different way because of the advances being made.”
Ferrial Syed who was badly burned as a toddler and became one of RAFT’s youngest patients to benefit from the charity’s lifesaving research said: “I often wonder how less traumatic my recovery would have been if RAFT’s Smart Matrix® had been available at the time of my accident. I look forward to the benefits it will give to patients in the future suffering similar traumas to their skin, major burns, military injuries, leg ulcers and so forth.”
For more information, go to https://raft.ac.uk/ or http://smartmatrix.co.uk/.
-Ends-
For further press information, please contact:
Jane Eggleton/Melissa Hobson/James Brooke
Rooster PR
T: +44 (0)20 3440 8925
E: RAFT@Rooster.co.uk
About RAFT
Restoration of Appearance and Function Trust (RAFT) is an innovative medical research charity working in the field of tissue and bone regeneration. The charity is a world-leader in creating pioneering new treatments for patients across the globe affected by wounds, burns and disease or birth abnormalities. The award-winning charity undertakes ground-breaking medical research to help patients regain their health, independence and self-esteem as quickly as possible after a trauma. RAFT’s vision is to bring forward the day when every patient who suffers a wound or severe tissue trauma fully regains their quality of life.
For nearly three decades RAFT has been undertaking pioneering scientific research that has changed the face of healthcare the world over. RAFT’s work has saved lives, improved treatments and recovery times, influenced healthcare policies around the world and changed laws. Today more than 100 of RAFT’s projects are in use in hospitals and clinics around the world.
RAFT was founded in 1988 by four plastic surgeons: Roy Sanders, Brian Morgan, Douglas Harrison and Paul Smith. Its founders set up the institute because they wanted to improve the speed at which scientific innovations could filter through to patients. RAFT has a long history of innovation and has played a major role in key medical advancements in the field over the past 30 years.
RAFT receives no Government funding and relies on donations and grants from individuals, grant-making trusts and companies. The team is working to raise more than £3 million over the next two years to allow the organisation to reach even more patients, even more quickly. RAFT aims to push back the boundaries of research, using the very latest technology and developing pioneering new techniques and treatments. The charity prides itself on being commercially forward-thinking and encourages social investment so that its research can be brought to patients more quickly.
For more information visit: https://raft.ac.uk/.
About Smart Matrix
Smart Matrix® was developed by RAFT in direct response to a significant and un-met clinical need. In order to carry out extensive clinical trials Smart Matrix Limited was formed and private equity was raised to pay for the trials.
Smart Matrix® is a UK-registered trademark (No: 2650438) in the classes of ‘surgical, medical, dental and veterinary apparatus and instruments’ and ‘scientific and technological services and research and design relating thereto’.
For more information visit: http://smartmatrix.co.uk/.
Related News.

Dr. Niccolo Caderni Named Chairman of RAFT
Innovative and award-winning medical research charity RAFT today announces the appointment of its new Chairman: Dr. Niccolo Caderni who will take over the role from...
Read more
Dr. Elena Garcia Promoted to Director of Research at RAFT
Award-winning medical research charity RAFT today announces it has promoted Dr Elena Garcia to Director of Research. Dr Garcia will be responsible for developing, directing...
Read more
Bonfire Night Burns & Artificial Skin
With around 1,000 people visiting A&E for treatment of a firework-related injury in the four weeks around Bonfire Night, medical research trust RAFT has even...
Read more
